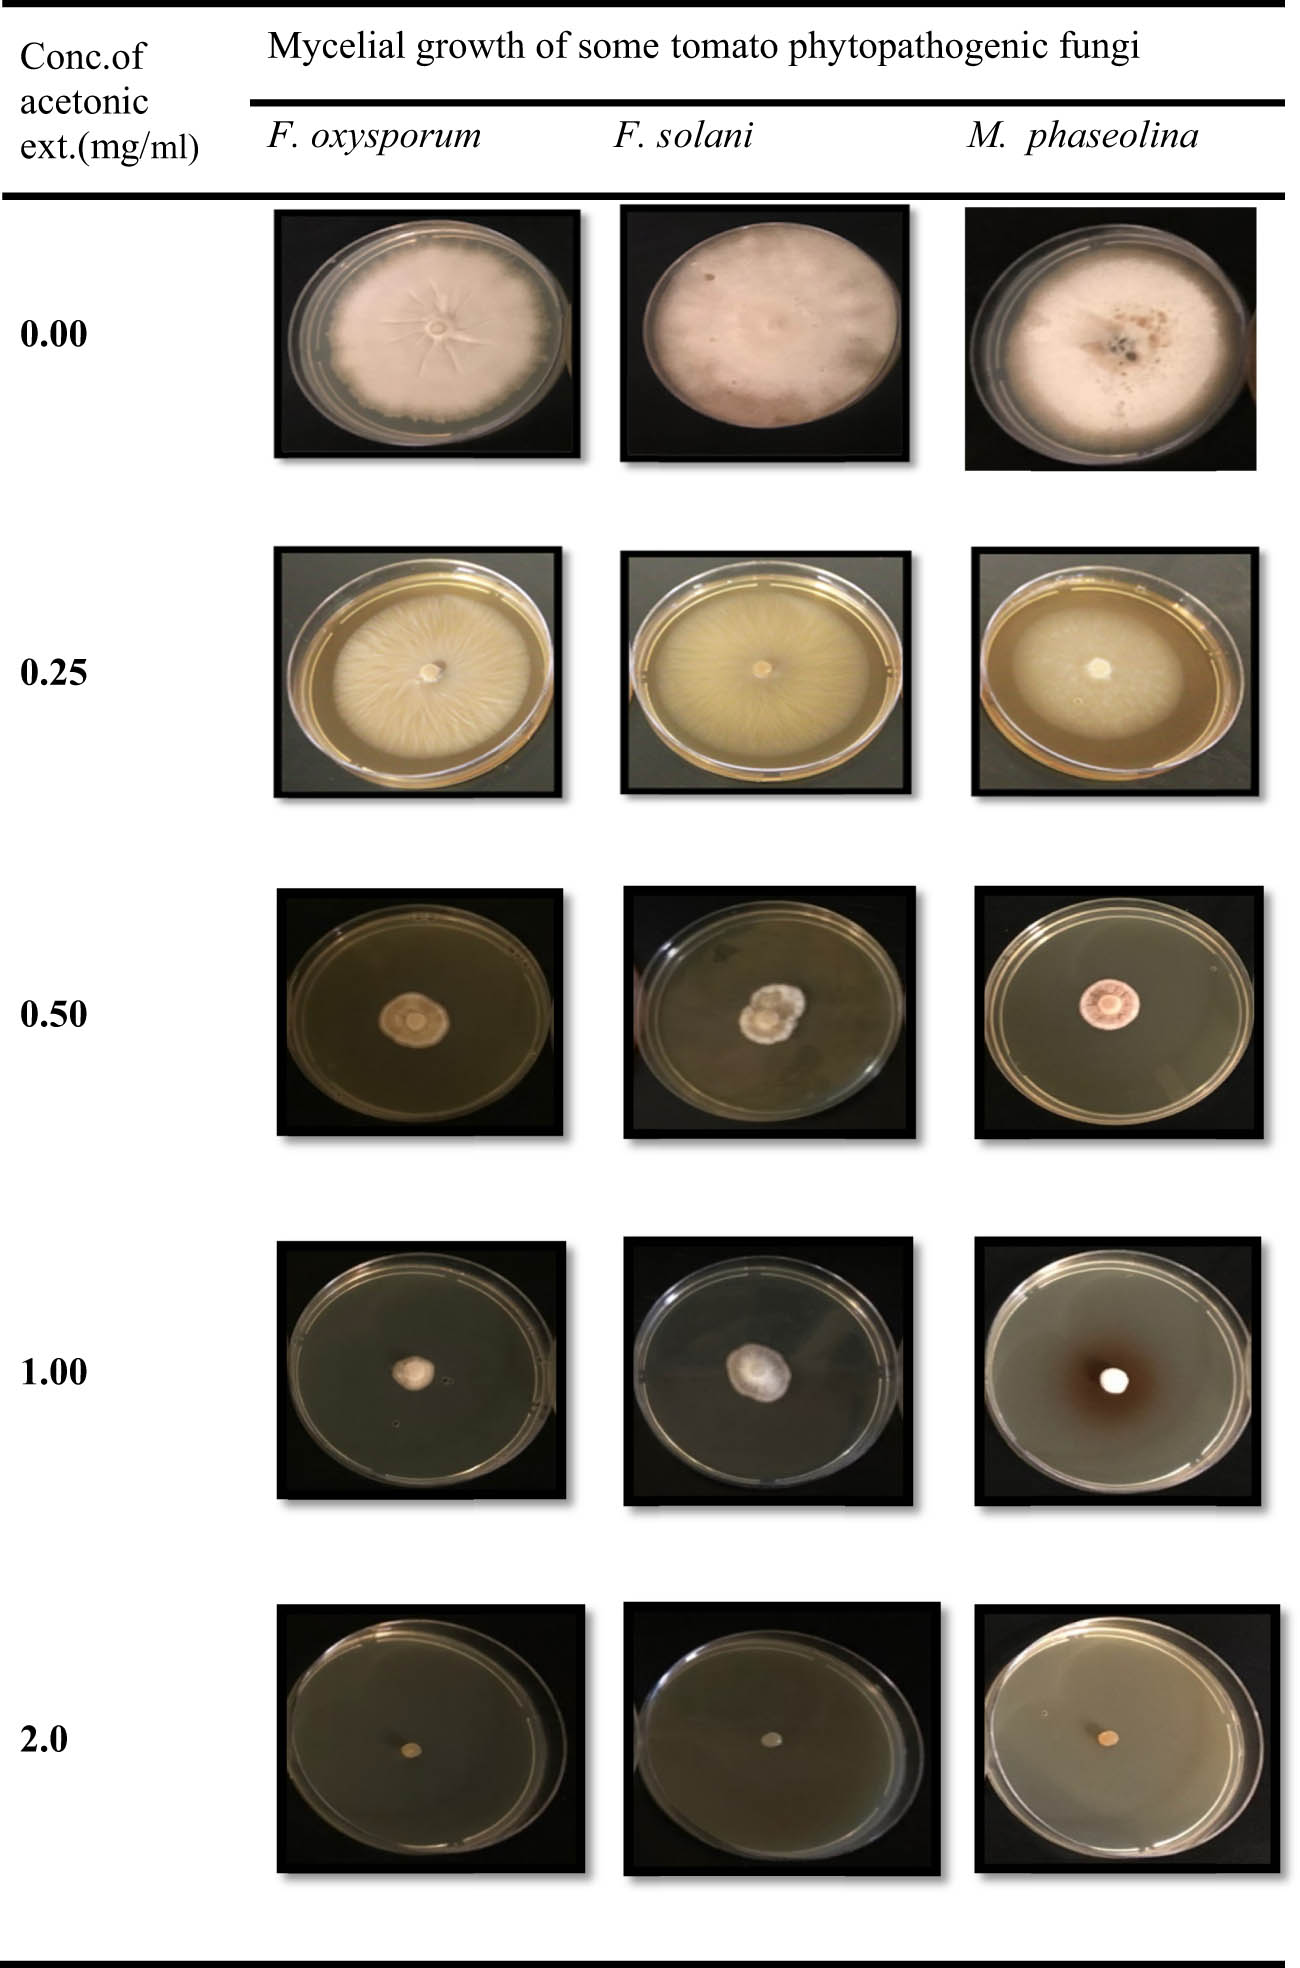
Figure 3
Evaluation of different concentrations of the acetonic marjoram extract against some tomato phytopathogens.

Abstract
Plant diseases represent one of the major problems causing yield loss of tomato crops, especially root rot and seedling damping-off diseases caused by some phytopathogenic fungi like Fusarium solani (Fs), F. oxysporum (Fo), and Macrophomina phaseolina (Mp) frequently detected in tomato either alone or in combination infection. The objective of the present study is to assess the antifungal activity of Origanum majorana extracts against the phytopathogenic fungi, Fs, Fo, and Mp, thereby avoiding controlling the disease with chemical fungicides. In this context, the acetonic extracts of O. majorana exhibited the highest antifungal activity against the tested phytopathogens. However, F. solani exhibited high resistance to Ridomil fungicide at the tested concentrations. A chemical analysis of the O. majorana acetonic extract was conducted to determine the main phytoactive constituents exhibiting fungicidal activity. In this regard, gas chromatography and mass spectrometry confirmed that 4-terpineol was the main phytoactive compound followed by γ-terpinolene exhibiting relative percentages of 24.36 and 8.26%, respectively. These results proved that the marjoram extract may contribute to the development of an alternative and natural fungicide to protect tomato crops from damping off and root rot diseases, avoiding the usage of chemical fungicides.
1 Introduction
Because of the widespread consumption of tomatoes as well as their nutritional and economic importance to farmers, tomatoes are regarded as an essential tropical crop [1]. Fusarium solani, F. oxysporum, and Macrophomina phaseolina are responsible for tomato seedling damping-off disease resulting in huge economic loss and poor quality of yield [2]. Seedling damping-off disease can be controlled by the application of chemical fungicides, the use of pathogen-resistant varieties, and crop rotation [3]. Although chemical fungicides have proven to be effective in preventing the spread of fungal diseases, their repeated use has led to sustained residual toxicity in tomatoes, environmental pollution, disturbing the soil’s biological ecology by killing the useful microflora and causing immense fungicide resistance development [4,5]. Recently, studies have been conducted on the development of biocontrol agents that could be effective and safer for the environment [6]. Within this context, the application of plant extracts as biological controls of tomato damping-off diseases was reviewed [7]. These plant extracts are recognized as safe for the environment, are natural sources of antimicrobials that are easily decomposed by soil microflora, and do not cause any health or environmental hazards [8,9,10,11,12,13,14,15,16]. Origanum majorana extracts are investigated as natural sources of bioactive agents that are environmentally safe, and they do not pose protracted health hazards at any concentration [17]. O. majorana extracts have been investigated to control plant diseases caused by bacterial and fungal plant pathogens [18]. There are numerous studies on pathogens that have been effectively controlled by the use of marjoram extracts such as Sclerotinia sclerotiorum [19], Verticillium dahliae, and Penicillium aurantiogriseum [20], Botrytis cinerea which cause gray mold disease in many plants [21], Aspergillus flavus, A. fumigatus, Microsporum gypseum, Cladosporium herbarium, Candida albicans, Cryptococcus neoformans, Trichophyton mentagrophytes [22], Candida albicans [17,23], Alternaria alternata, Bipolaris oryzae, Fusarium graminearum, Fusarium equiseti, and Fusarium verticillioides [24]. Although the number of bio-control agents is developing, they still represent only a tiny proportion of applicable biocides. Consequently, there is a crucial need to find alternative approaches for controlling damping-off and root rot diseases in tomatoes. However, the use of O. majorana extracts as biocontrol agents against tomato phytopathogenic fungi has received far less attention [25]. Therefore, the objectives of the present study were planned to evaluate the antifungal activity of Origanum extracts against some phytopathogenic fungi (Fusarium oxysporum (Fo), F. solani (Fs), and M. phaseolina (Mp)) causing tomato damping-off disease and to compare efficacy of Origanum extracts as biocontrol agent with that of reference fungicide (Ridomil) in prevention of tomato phytopathogenic fungi in vitro.
2 Materials and methods
2.1 Preparation of O. majorana extracts
Marjoram was purchased from Riyadh markets, Saudi Arabia. The plant (O. majorana) was identified and deposited with voucher number KSU-16653 by the herbarium of the Botany Department, College of Science, King Saud University. The active phytochemicals of Marjoram were extracted using four different solvents (ethanol, methanol, acetone, and distilled water) with corresponding polarity indexes of 4.3, 5.1, 5.1, and 10.2, respectively. A difference in the polarity of the used solvents allows the extraction of all active phytochemicals [26]. Disinfection of marjoram was performed using 0.5% sodium hypochloride (NaOCl) followed by washing of the plant three successive times with distilled water, and finally, the plant was left in the shade to dry. Maceration of the plant was done to attain a homogenized fine powder. Plant extracts were prepared by soaking 50 g of plant powder in four solvents (10 ml of solvent/g of plant powder) with stirring for 48 h, filtered through double layers of muslin, and filtered again through Whatman filter paper No. (41) to remove plant debris. and finally centrifuged at 9,000 rpm for 10 min to obtain a clear filtrate. The supernatants of all extracts were evaporated using a rotatory evaporator to concentrate the marjoram extracts and then refrigerated at 4°C until used.
2.2 Fungal cultures
Fungal cultures of F. oxysporum ATCC-52422, Fusarium solani ATTC-11712, and M. phaseolina ATCC-64334 were provided from the culture collection of the Plant Pathology Lab. at Botany and Microbiology Department, King Saudi University, Riyadh, K.S.A. The cultures were renewed on potato dextrose agar (PDA) plates, preserved in slants, and stored in a fridge at 5°C until used.
2.3 Screening of antifungal activity of marjoram extracts
Antifungal activity was evaluated on tomato phytopathogenic fungi using the food poisoning technique (Mostafa et al., 2013). Sticky plant extracts were re-dissolved in (5 ml) the corresponding solvent, sterilized with a Millipore filter (0.22 µm pores), and mixed with sterile PDA medium to obtain a final concentration of 1.0 mg ml−1 of the marjoram extract and then poured in sterile Petri dishes (90 mm diameter). For control, 5 ml of Millipore-sterilized solvents was added to (PDA) plates. Discs of 7 mm diameter of phytopathogenic fungi were cut from the periphery of 6 days actively growing cultures and placed over the center of Petri dishes of treatment and control sets and then incubated at 25°C ± 2°C for 7 days. The fungal colony diameter of treatments and control sets were measured using Vernier calipers, and the inhibition of mycelial growth was computed using the following formula: Inhibition of fungal mycelial growth (%) = (DC − DT)/DC × 100 (where DC and DT are the fungal colony diameters (mm) in control and treatment).
2.4 Efficiency of standard fungicide (Ridomil Gold) against tomato phytopathogenic fungi
The antifungal efficacy of Mefenoxam (Metalaxyl-M) with trade name (Ridomil Gold SL, 48%) was evaluated using a food poisoning technique. Different concentrations of Mefenoxam (active ingredient) (0.0, 0.125, 0.25, 0.5, 1.0, and 2.0 ppm) were prepared by mixing a measured volume of fungicide with a known volume of sterile (PDA). Fungal plugs of phytopathogenic fungi (7 mm in diameter) were obtained and placed at the center of Petri dishes containing PDA medium, supplemented with various concentrations of fungicide. The plates were incubated at 25°C ± 2°C, and the radial growth of the phytopathogenic fungi, on both control and treated plates, was estimated using Vernier calipers, and the growth inhibition percentage was computed.
2.5 Fungicidal bioassay of marjoram extracts
The marjoram (O. majorana) extract was manipulated to determine its minimal inhibitory concentration (MIC) and minimal fungicidal concentrations (MFCs) to evaluate its efficiency in controlling tomato phytopathogenic fungi compared with standard fungicide (Ridomil Gold SL, 48%).
2.5.1 Detection of MICs of O. majorana
The MIC values were determined as the minimal concentration at which minimal growth was observed compared to the control. MIC was evaluated for the acetonic extract of O. majorana as it demonstrated the highest antifungal efficiency. Different concentrations of the acetonic marjoram extract (0.0, 0.5, 1.0, 2.0, and 4.0 mg/ml) were prepared separately by dissolving their requisite amount in a 10 ml of acetone, sterilized through a Millipore filter, and mixed with the PDA medium to obtain their final concentrations. Fungal discs of pathogenic fungi (7 mm in diameter) were placed at the center of Petri dishes containing PDA medium of various marjoram extract concentrations. The plates were incubated at 25°C ± 2°C, and the fungal growth was measured by Vernier calipers after 6 days. The antimycotic efficacy of the marjoram extract was compared with the fungicidal potency of the reference fungicide with three replications. The fungicidal bioactivity of the marjoram extract was computed and MIC was detected.
2.5.2 Detection of MFC
The MFCs of the acetonic marjoram extract were achieved by picking agar discs from plates showing no visible fungal growth, inoculating on sterile PDA plates, and then incubating at 25°C for 7 days. After incubation, plates showing complete inhibition of fungal growth were recorded as the MFC.
2.6 Ultracellular effect of the acetonic marjoram extract on the fungal cells of phytopathogens using SEM
Mycelial strips of F. solani were selected to demonstrate the effect of the acetonic marjoram extract on the fungal cell morphology. Hyphal strips were obtained from marjoram-treated plates grown on PDA of concentration 1 mg/ml and fixed in 2.5% glutaraldehyde/sodium phosphate buffer (0.13 M, pH 7.2) overnight. The specimens were washed three times with buffer and then post-fixed in osmium tetraoxide for 2 h, washed again with buffer, and dehydrated using increasing ethanol levels (30–100%) for 15 min at each step. The specimens were dried at the critical point and coated with carbon to be examined using a scanning electron microscope (JEOL JSM-6380 LA) operating at 20 kV.
2.7 Gas chromatography and mass spectrometry (GC-MS) analysis of the acetonic marjoram extract
Acetonic extract of marjoram (O. majorana) was analyzed using a GC-MS Agilent system (model GC-7890B-MS-5975, Agilent Technologies, USA). The analysis was carried out using an HP5MS capillary column (30 m × 0.25 mm; 0.25 μm film thickness). The operating conditions were as follows: injection and detector temperature, 250 and 300°C, respectively; carrier gas, helium with a flow rate of 1.0 ml/min. The initial oven temperature program was 50–300°C, increased at a rate of 5°C/min, then by 9°C/min to 250°C. Mass spectrometer conditions were as follows: ionization potential, 70 eV; mass range from m/z, 50–650 amu; and electron multiplier energy, 2,000 V. The total run time was 60 min and the bioactive compounds of the Majoram extract were identified by comparison of their relative retention times and the mass spectra with those authentic reference compounds shown in the literature and by computer matching of their MS spectra with Wiley and Nist, 8 mass spectral library [26].
2.8 Statistical analysis
All experiments were performed in three replicates for each treatment. The data were reported as mean ± SE (standard error) and analyzed statistically using a one-way analysis of variance. Differences among the mean values were determined for significance at P ≤ 0.05 (by SPSS, 16.1 Chicago, USA).
3 Results
3.1 Screening of antifungal activity of marjoram extracts
The antifungal activity of marjoram (O. majorana) extracts was screened and evaluated against some tomato phytopathogenic fungi (F. oxysporum, F. solani, and M. phaseolina) in vitro (Table 1). The acetonic extract of marjoram at 1 mg/ml was highly effective in suppressing the mycelial growth of F. oxysporum, F. solani, and M. phaseolina to 78.13, 72.92, and 83.33% compared to the non-treated control. The marjoram ethanolic extract was moderately effective in reducing the mycelial growth of all concerned tomato phytopathogens to 55.17, 60.42, and 56.25% respectively, while methanolic and aqueous extracts of marjoram were less efficient in controlling the studied phytopathogenic fungi.
Antifungal screening test of different marjoram extracts (1 mg/ml) against tomato phytopathogenic fungi
| Marjoram-extract conc. (1 mg/ml) | Diameter of mycelial fungal growth (mm) | Percentage of mycelial growth inhibition | ||||
|---|---|---|---|---|---|---|
| Fo | Fs | Mp | Fo | Fs | Mp | |
| Ethanolic extract | 3.58* ± 0.17 | 3.17* ± 0.46 | 3.5 ± 0.14 | 55.17 | 60.42 | 56.25 |
| Methanolic extract | 5.85* ± 0.08 | 6.25* ± 0.14 | 4.17* ± 0.08 | 30.21 | 21.88 | 47.92 |
| Acetonic extract | 1.75± 0.43 | 2.17 ± 0.12 | 1.33 ± 0.23 | 78.13 | 72.92 | 83.33 |
| Aqueous extract | 7.00 ± 0.06 | 6.17 ± 0.17 | 6.0* ± 0.14 | 12.50 | 22.92 | 25.00 |
| Control (00.0) | 8.00 ± 0.13 | 8.00 ± 0.10 | 8.00 ± 0.11 | — | — | — |
* Fo: Fusarium oxysporum; Fs: Fusarium solani; Mp: Macrophomina phaseolina.
Values in the same column followed by asterisk (*) are significantly different at P = 0.05.
Data are mean (n = 3) ± SE of three replicates.
3.2 Efficiency of standard fungicide (Ridomil Gold) against tomato phytopathogenic fungi
M. phaseolina was the most sensitive fungal isolate to Ridomil-Gold fungicide at a concentration of 0.5 ppm, F. oxysporum was moderately affected, whereas F. solani was resistant to ridomil as shown in Table 2. At a concentration of 1.0 ppm, ridomil prevented the mycelial growth of M. phaseolina completely and inhibited the F. oxysprum and F. solani by 67.25 and 53.5%, respectively. Moreover, the fungicidal activity of ridomil against the tomato phytopathogens was obvious and completely suppressed the fungal growth of M. phaseolina and F. oxysporum and inhibited the growth of F. solani to 80.38% at a concentration of 2.00 ppm, respectively. Ridomil-Gold was strongly effective against M. phaseolina with an MIC of 0.125 ppm and an MFC of 1.0 ppm while it showed fungistatic activity against F. oxysporum with an MIC of 1.0 and an MFC of 2 ppm.
Antifungal efficiency of standard fungicide (Ridomil-Gold) against some tomato phytopathogenic fungi
| Ridomil-Gold conc. (ppm) | Diameter of the mycelial fungal growth (mm) | Inhibition of the mycelial fungal growth percentage | ||||
|---|---|---|---|---|---|---|
| Fo | Fs | Mp | Fo | Fs | Mp | |
| 0.000 | 80.0 ± 0.00 | 80.0 ± 0.00 | 80.0 ± 0.00 | — | — | — |
| 0.125 | 57.7* ± 1.21 | 60.0* ± 2.13 | 46.7* ± 1.12 | 27.88 | 25.00 | 41.63 |
| 0.250 | 52.3* ± 1.09 | 58.3 ± 1.46 | 19.2* ± 1.04 | 34.63 | 27.13 | 76.00 |
| 0.500 | 44.4* ± 0.49 | 51.0 ± 1.83 | 0.00 ± 0.00 | 44.50 | 36.25 | 100.0 |
| 1.000 | 26.2 ± 0.19 | 37.2 ± 1.39 | 0.00 ± 0.00 | 67.25 | 53.50 | 100.0 |
| 2.000 | 0.00 ± 0.00 | 15.7 ± 1.75 | 0.00 ± 0.00 | 100.0 | 80.38 | 100.0 |
Fo: Fusarium oxysporum; Fs: Fusarium solani; Mp: Macrophomina phaseolina.Values in the same column followed by asterisk (*) are significantly different at P = 0.05.
Data are means (n = 3) ± SE of three replicates.
3.3 Fungicidal bioassay of marjoram extracts
The acetonic extract of O. majorana was highly efficient and showed fungicidal and fungistatic activities against the concerned F. oxysporum, F. solani, and M. phaseolina with an MIC of 0.5 mg/ml and an MFC of 2 mg/ml, respectively (Table 3). The concentration effect of the acetonic marjoram extract (O. majorana) on the mycelial growth of tomato phytopathogens is shown in Figure 1 and plotted against the mycelial growth of the respective fungi (Figure 2). However, differences in the antifungal activities of the marjoram acetonic extract against tomato phytopathogenic fungi were highly significant at P > 0.05. F. oxysporum and M. phaseolina were significantly susceptible (P ≤ 0.05) to the marjoram acetonic extract, compared with the control, while F. solani was less susceptible. Growth inhibitions of phytopathogenic fungi were increased as the concentrations reached 80.89, 76.13, and 85.63% at 1 mg/ml and completely stifled at 2 mg/ml of the extract (Figure 3).
Evaluation of different concentrations of the acetonic marjoram extract against some tomato phytopathogens
| Acetonic marjoram-extract Conc. (mg/ml) | Diameter of mycelial fungal growth (mm) | Percentage of mycelial growth inhibition | ||||
|---|---|---|---|---|---|---|
| Fo | Fs | Mp | Fo | Fs | Mp | |
| 0.00 | 80.0 ± 0.00 | 80.0 ± 0.00 | 80.0 ± 0.00 | 0.00 | 0.00 | 0.00 |
| 0.25 | 74.2 ± 0.97 | 75.5 ± 1.16 | 69.8 ± 1.24 | 7.25 | 5.63 | 12.75 |
| 0.50 | 36.5* ± 0.48 | 40.8* ± 0.92 | 30.2 ± 0.58 | 54.38 | 49.00 | 62.25 |
| 1.00 | 15.3* ± 1.32 | 19.1* ± 0.68 | 11.5 ± 0.86 | 80.89 | 76.13 | 85.63 |
| 2.00 | 0.00 ±0.00 | 0.00 ± 0.00 | 0.00 ± 0.00 | 100.0 | 100.0 | 100.0 |
Fo: Fusarium oxysporum; Fs: Fusarium solani; Mp: Macrophomina phaseolina.Values in the same column followed by asterisk (*) are significantly different at P = 0.05.
Data are mean (n = 3) ± SE of three replicates.

Antifungal efficiency of standard fungicide (Ridomil-Gold) against some tomato phytopathogenic fungi.

Evaluation of the antifungal efficiency of different concentrations of the acetonic marjoram extract against some tomato phytopathogens.
Evaluation of different concentrations of the acetonic marjoram extract against some tomato phytopathogens.
Finally, the O. majorana acetonic extract had fungistatic and fungicidal activities against all tested fungi with MICs of 0.5 mg/ml, suppressed fungal growth strongly at 1 mg/ml, and showed MFCs of 2 mg/ml for all tested fungi.
3.4 Ultracellular effect of the acetonic marjoram extract on the fungal cells of phytopathogens using SEM
The morphological and ultrastructure characterization of F. solani (which was selected as a model for fungal growth changes) in response to the acetonic marjoram extract using an SEM revealed dramatic alterations to the morphology and ultrastructure of the test pathogen in comparison to the control. The SEM results of the F. solani (untreated) were characterized by lengthened hyphae, of constant diameter, sub-parallel and with rounded or lightly tapering apex, smooth external surface with the presence of conidia, and the growth was very dense. Meanwhile, most of the formed fungal mycelia appeared to grow parallel and adherent at 800× power (Figure 4a). By contrast, the SEM micrographs of F. solani treated with 1 mg/ml O. majorana extract, clearly showed curly hyphae, varied diameter, irregular branching hyphae (Figure 4b), deformed, wrinkled external surfaces, and incomplete growth of apex (Figure 4c). Also, the presence of chlamydospores, besides the formed conidia, was embedded and overlapped (Figure 4d). Similar damage to morphology and ultrastructure of fungal cells when treated with different plant extracts was reported [27,28].

Scanning electron microphotographs of F. solani cells treated with the O. majorana ethanol extract at a concentration of 1 mg/ml. Control: untreated (a) and treated: (b)–(d).
3.5 GC-MS analysis of the acetonic marjoram extract
The acetonic marjoram extract was chemically analyzed by GC-MS to estimate and identify the chemical constituents of the extract. The compound name, chemical formula, molecular weight, and structure of marjoram constituents are given in Table 4. The analysis revealed the presence of various bioactive phytochemical compounds, mainly terpines and terpines derivatives like 4-terpineol, γ-terpinolene, β-terpineol, α-terpineol, camphene, α-phellandrene, carvacol, 6-methyl-6-hepten-4-Yn-2-Ol, 1,5-hexadiyne, and undecanal, which may be responsible for the growth inhibition of tomato phytopathogenic fungi.
Phytochemical components of the acetonic marjoram (O. majorana) extract
| Retention time | Compound name | Structural formula | Molecular weight (g mol−1) | Peak area % |
|---|---|---|---|---|
| 5.13 | Pyridine borane |

|
92.94 | 0.27 |
| 5.48 | 1,5-Hexadiyne |

|
78.11 | 0.34 |
| 5.62 | 3-Thujene |

|
136.24 | 1.18 |
| 5.90 | n-Undecanal |

|
170.29 | 0.65 |
| 6.14 | 2-pinene |

|
136.24 | 2.74 |
| 6.47 | Camphene |

|
136.24 | 6.28 |
| 6.85 | α-Phellandrene |

|
136.24 | 3.81 |
| 6.94 | 6-Methyl-6-hepten-4-Yn-2-Ol |

|
124.18 | 0.46 |
| 7.03 | Myrcene |

|
136.24 | 1.14 |
| 7.15 | 3-Carene |

|
136.24 | 2.36 |
| 7.32 | α-Terpilene |

|
136.23 | 8.73 |
| 7.85 | p-Cymene |

|
134.22 | 5.21 |
| 8.47 | Sabinene |

|
136.23 | 3.17 |
| 9.62 | γ-Terpinolene |

|
136.23 | 12.83 |
| 10.22 | Carvacrol |

|
150.22 | 0.56 |
| 13.56 | β-Terpineol |

|
154.25 | 8.26 |
| 13.64 | Cineol |

|
154.25 | 2.47 |
| 13.97 | Isoborneol |

|
154.25 | 3.14 |
| 14.69 | 4-Terpineol |

|
154.25 | 24.36 |
| 15.23 | α-Terpineol |

|
154.25 | 6.38 |
| 16.51 | Linalool |

|
154.25 | 1.15 |
| 19.71 | Caryophyllene |

|
204.36 | 2.18 |
| 22.14 | γ-Elemene |

|
204.36 | 0.61 |
4 Discussion
Chemical fungicides are applied to control damping-off infections in tomato seedlings. Since fungicides are thought to be responsible for a number of carcinogenic and teratogenic attributes as well as residual toxicity, there is considerable debate about the safety aspects of those currently in use. Finding natural and efficient alternatives for chemical fungicides against fungal plant pathogens is of increasing importance as the trend toward eco-friendly organic production methods in agriculture expands [29]. In this context, tomato damping-off diseases can be controlled using plant extracts like the acetonic marjoram extract. To assess the effectiveness of the marjoram extract in preventing tomato phytopathogenic fungi, it was evaluated in vitro at a concentration of 1 mg/ml against F. oxysporium, F. solani, and M. phaseolina.
Assays revealed that the O. majorana extract provided a significant inhibition of mycelial growth of all relevant phytopathogenic fungi and their sensitivity varied extensively. The O. majorana extract was highly effective in suppressing the mycelial growth of M. phaseolina and F. oxysporum and inhibited to 83.33 and 78.13%, while F. solani was less sensitive and its mycelial growth and was inhibited to 72.92% at 1 mg/ml. These results are in accordance with those of Dhaouadi et al. and Raouafi et al. [30,31]. A variation in fungi toxicity of the acetonic marjoram extract against tomato phytopathogenic fungi may be due to variation in the fungal species itself [32,33].
The study of MIC and MFC of the fungi toxicants compared with reference fungicide is necessary to evaluate their efficacy in suppressing mycelial growth of the phytopathogenic fungi. The marjoram extract was strongly active against the tomato phytopathogenic fungi but its MIC and MFC were comparatively higher than that of the reference fungicide. However, Ridomil-Gold SL 48% fungicide was the most effective fungi toxicant suppressing the growth of phytopathogenic fungi than marjoram extracts, as the mycelial growth of the three phytopathogenic fungi was completely inhibited at 2 ppm while a concentration of 2 mg/ml was required for the marjoram extract to attain the same effect.
Antifungal compounds present in the O. majorana extract were analyzed by GC-MS and 23 compounds were identified. Della-Pepa et al. identified terpinen-4-ol and carvacol as the primary bioactive constituents of O. majorana extracts using GC-MS analysis. Furthermore, Della-Pepa et al. observed that these extracts exhibited fungi toxic properties [34].
Hajlaoui et al. stated that the antifungal potency of the marjoram extract can be attributed to the major constituents of monoterpenes or the synergetic effect of these compounds [35]. Kadoglidou et al. showed that the concentration of oxygenated compounds directly affected the antifungal activity [36]. Vagi et al. and Adams and Ahmed reported that terpinen-4-ol was the main active compound for the antifungal activity [37,38]. Eventually, the antimycotic potency of the essential oil depended on the composition and concentration of the marjoram extract [39].
5 Conclusions
The antifungal potency of the O. majorana extract gives a new opportunity to control tomato damping-off diseases that cause damage at the seedling stage, especially in condensed agriculture. The present study showed that the application of marjoram extract as a bioagent was found to be effective in the suppression of some fungi causing tomato damping-off diseases. These results proved that the marjoram extract may contribute to the development of an alternative and natural fungicide to protect tomato crops from damping-off and root rot diseases, avoiding the usage of chemical fungicides.
Acknowledgments
The authors extend their appreciation to the Researchers Supporting Project number (RSP2023R114), King Saud University, Riyadh, Saudi Arabia for funding this work.
-
Funding information: This research project was supported by a grant from the Researchers Supporting Project number (RSP2023R114), King Saud University, Riyadh, Saudi Arabia.
-
Author contributions: Fatimah Al-Otibi contributed to the writing and original draft preparation. Reem A. Alshahrani contributed to the investigation, and data curation. Raedah I. Alharbi contributed to the formal analysis of results. Mohamed Taha Yassin contributed to the writing of the original draft, reviewing, and editing.
-
Conflict of interest: The authors confirm that there is no conflict of interest.
-
Ethical approval: The conducted research is not related to either human or animal use.
-
Data availability statement: All data generated or analyzed during this study are included in this published article and its supplementary information files.
References
[1] Kittas C, Katsoulas N, Rigakis V, Bartzanas T, Kitta E. Effects on microclimate, crop production and quality of a tomato crop grown under shade nets. J Hortic Sci Biotechnol. 2012;87(1):7–12.10.1080/14620316.2012.11512822Search in Google Scholar
[2] Abo-Elyousr KA, Ali EF, Sallam NM. Alternative control of tomato wilt using the aqueous extract of calotropis procera. Horticulturae. 2022;8(3):197.10.3390/horticulturae8030197Search in Google Scholar
[3] Mohamed HA, Nasr F, Abdelkreem KI. Management of tomato damping-off disease caused by Fusarium oxysporum and Rhizoctonia solani using chemical and biological degradable olive mill waste water. Egypt J Biol Pest Control. 2015;25(2):367–77.Search in Google Scholar
[4] Huang X, Zhang N, Yong X, Yang X, Shen Q. Biocontrol of Rhizoctonia solani damping-off disease in cucumber with Bacillus pumilus SQR-N43. Microbiol Res. 2012;167(3):135–43.10.1016/j.micres.2011.06.002Search in Google Scholar PubMed
[5] Mostafa AA, Al-Rahmah AN, Yakout SM, Abd-Alrahman SH. Bioactivity of garlic bulb extract compared with fungicidal treatment against tomato phytopathogenic fungi. J Pure Appl Microbiol. 2013;7:1925–32.Search in Google Scholar
[6] Shakya AK. Medicinal plants: Future source of new drugs. Int J Herb Med. 2016;4(4):59–64.Search in Google Scholar
[7] Bouzidi N, Mederbal K. Biological control of damping-off and root-rot diseases. Electron J Biol. 2016;12(1):38–42.Search in Google Scholar
[8] Abdelhamed FM, Abdeltawab NF, ElRakaiby MT, Shamma RN, Moneib NA Antibacterial and anti-inflammatory activities of thymus vulgaris essential oil nanoemulsion on acne vulgaris. Microorganisms. 2022 Sep [cited 2022 Dec 28];10(9):1874. https://www.mdpi.com/2076-2607/10/9/1874.10.3390/microorganisms10091874Search in Google Scholar PubMed PubMed Central
[9] Sateriale D, Forgione G, De Cristofaro GA, Facchiano S, Boscaino F, Pagliuca C, et al. Towards green strategies of food security: Antibacterial synergy of essential oils from thymus vulgaris and Syzygium aromaticum to inhibit escherichia coli and staphylococcus aureus pathogenic food isolates. Microorganisms. 2022 Dec [cited 2022 Dec 28];10(12):2446. https://www.mdpi.com/2076-2607/10/12/2446.10.3390/microorganisms10122446Search in Google Scholar PubMed PubMed Central
[10] Wang W, Chen YF, Wei ZF, Jiang JJ, Peng JQ, He QT, et al. Microemulsion of cinnamon essential oil formulated with tea polyphenols, gallic acid, and tween 80: Antimicrobial properties, stability and mechanism of action. Microorganisms. 2023 Jan [cited 2022 Dec 28];11(1):2. https://www.mdpi.com/2076-2607/11/1/2.10.3390/microorganisms11010002Search in Google Scholar PubMed PubMed Central
[11] Ramaiah AK, Garampalli RKH. In vitro antifungal activity of some plant extracts against Fusarium oxysporum f. sp. lycopersici. Asian J Plant Sci Res. 2015;5(1):22–7.Search in Google Scholar
[12] Chohan S, Perveen R, Abid M, Naqvi AH, Naz S. Management of seed borne fungal diseases of tomato: a review. Pak J Phytopathol. 2017;29(1):193–200.10.33866/phytopathol.029.01.0274Search in Google Scholar
[13] Hernández-Ceja A, Loeza-Lara PD, Espinosa-García FJ, García-Rodríguez YM, Medina-Medrano JR, Gutiérrez-Hernández GF, et al. In vitro antifungal activity of plant extracts on pathogenic fungi of blueberry (Vaccinium sp.). Plants. 2021;10(5):852.10.3390/plants10050852Search in Google Scholar PubMed PubMed Central
[14] Kaigongi MM, Lukhoba CW, Yaouba S, Makunga NP, Githiomi J, Yenesew A. In vitro antimicrobial and antiproliferative activities of the root bark extract and isolated chemical constituents of Zanthoxylum paracanthum Kokwaro (Rutaceae). Plants. 2020;9(7):920.10.3390/plants9070920Search in Google Scholar PubMed PubMed Central
[15] Seepe HA, Lodama KE, Sutherland R, Nxumalo W, Amoo SO. In vivo antifungal activity of South African medicinal plant extracts against Fusarium pathogens and their phytotoxicity evaluation. Plants. 2020;9(12):1668.10.3390/plants9121668Search in Google Scholar PubMed PubMed Central
[16] El-Shahir AA, El-Wakil DA, Abdel Latef AAH, Youssef NH. Bioactive compounds and antifungal activity of leaves and fruits methanolic extracts of Ziziphus spina-christi L. Plants. 2022;11(6):746.10.3390/plants11060746Search in Google Scholar PubMed PubMed Central
[17] Lakhrissi B, Boukhraz A, Barrahi M, Hartiti HE, Ouhssine M. Antifungal activity of essential oil of oregano (Origanum vulgare), marjoram (Origanum majorana) and synergy of two essential oils against Candida albicans. Int J Res Stud Sci Eng. 2016;3:14–7.Search in Google Scholar
[18] Cherkupally R, Kota SR, Amballa H, Reddy BN. In vitro antifungal potential of plant extracts against Fusarium oxysporum, Rhizoctonia solani and Macrophomina phaseolina. Ann Plant Sci. 2017;6(9):1676–80.10.21746/aps.2017.9.2Search in Google Scholar
[19] Soylu S, Yigitbas H, Soylu EM, Kurt Ş. Antifungal effects of essential oils from oregano and fennel on Sclerotinia sclerotiorum. J Appl Microbiol. 2007;103(4):1021–30.10.1111/j.1365-2672.2007.03310.xSearch in Google Scholar PubMed
[20] Rus CF, Pop G, Alexa E, Umălan RM, Copolovici DM. Antifungal activity and chemical composition of Origanum majorana L. essential oil. Res J Agric Sci. 2015;47(2):179–85.Search in Google Scholar
[21] Soylu EM, Kurt Ş, Soylu S. In vitro and in vivo antifungal activities of the essential oils of various plants against tomato grey mould disease agent Botrytis cinerea. Int J Food Microbiol. 2010;143(3):183–9.10.1016/j.ijfoodmicro.2010.08.015Search in Google Scholar PubMed
[22] Souza NAB, Lima EdeO, Guedes DN, Pereira FdeO, Souza ELde, Sousa FBde. Efficacy of Origanum essential oils for inhibition of potentially pathogenic fungi. Braz J Pharm Sc. 2010;46:499–508.10.1590/S1984-82502010000300013Search in Google Scholar
[23] Kaskatepe B, Aslan Erdem S, Ozturk S, Safi Oz Z, Subasi E, Koyuncu M, et al. Antifungal and anti-virulent activity of origanum majorana L. Essential oil on candida albicans and in vivo toxicity in the Galleria Mellonella larval model. Molecules. 2022 Jan [cited 2022 Dec 26];27(3):663. https://www.mdpi.com/1420-3049/27/3/663.10.3390/molecules27030663Search in Google Scholar PubMed PubMed Central
[24] Santamarina MP, Roselló J, Sempere F, Giménez S, Blázquez MA. Commercial Origanum compactum Benth. and Cinnamomum zeylanicum Blume essential oils against natural mycoflora in Valencia rice. Nat Prod Res. 2015;29(23):2215–8.10.1080/14786419.2014.1002406Search in Google Scholar PubMed
[25] Leeja L, Thoppil JE. Antimicrobial activity of methanol extract of Origanum majorana L. (Sweet marjoram). J Environ Biol. 2007 Jan;28(1):145–6.Search in Google Scholar
[26] Yassin MT, Mostafa AAF, Al-Askar AA. In vitro anticandidal potency of Syzygium aromaticum (clove) extracts against vaginal candidiasis. BMC Complement Med Ther. 2020;20(1):1–9.10.1186/s12906-020-2818-8Search in Google Scholar PubMed PubMed Central
[27] Alotibi FO, Ashour EH, Al-Basher G. Evaluation of the antifungal activity of Rumex vesicarius L. and Ziziphus spina-christi (L) Desf. Aqueous extracts and assessment of the morphological changes induced to certain myco-phytopathogens. Saudi J Biol Sci. 2020;27(10):2818–28.10.1016/j.sjbs.2020.06.051Search in Google Scholar PubMed PubMed Central
[28] Rizwana H, Alwhibi MS, Al-Judaie RA, Aldehaish HA, Alsaggabi NS. Sunlight-mediated green synthesis of silver nanoparticles using the berries of Ribes rubrum (red currants): Characterisation and evaluation of their antifungal and antibacterial activities. Molecules. 2022;27(7):2186.10.3390/molecules27072186Search in Google Scholar PubMed PubMed Central
[29] Tripathy B, Satyanarayana S, Khan KA, Raja K, Mohanty C. Phytochemical screening and antifungal activity of ethanol and petroleum-ether leaf extracts of Origanum majorana. Int J Pharm Res Health Sci. 2016;4(4):1320–3.10.21276/ijprhs.2016.04.14Search in Google Scholar
[30] Dhaouadi S, Rouissi W, Mougou-Hamdane A, Hannachi I, Nasraoui B. Antifungal activity of essential oils of Origanum majorana and Lavender angustifolia against Fusarium wilt and root rot disease of melon plants. Tunis J Plant Prot. 2018;13:39–55.Search in Google Scholar
[31] Raouafi K, Nefzi H, Esghaier B, Sadfi N, Abderrabba M, Sameh Ayadi S. Biological activity and characterization of essential oil of areal part from Origanum majorana L.: First report of antifungal activity against Fusarium oxysporum and against his biofilm. J Mater Environ Sci. 2021;12:746–56.Search in Google Scholar
[32] Kumar V, Mathela CS, Tewari AK, Bisht KS. In vitro inhibition activity of essential oils from some Lamiaceae species against phytopathogenic fungi. Pestic Biochem Physiol. 2014;114:67–71.10.1016/j.pestbp.2014.07.001Search in Google Scholar PubMed
[33] Thanh VM, Bui LM, Bach LG, Nguyen NT, Thi HL, Hoang Thi TT. Origanum majorana L. essential oil-associated polymeric nano dendrimer for antifungal activity against Phytophthora infestans. Materials. 2019;12(9):1446.10.3390/ma12091446Search in Google Scholar PubMed PubMed Central
[34] Della Pepa T, Elshafie HS, Capasso R, De Feo V, Camele I, Nazzaro F, et al. Antimicrobial and phytotoxic activity of Origanum heracleoticum and O. majorana essential oils growing in Cilento (Southern Italy). Molecules. 2019;24(14):2576.10.3390/molecules24142576Search in Google Scholar PubMed PubMed Central
[35] Hajlaoui H, Mighri H, Aouni M, Gharsallah N, Kadri A. Chemical composition and in vitro evaluation of antioxidant, antimicrobial, cytotoxicity and anti-acetylcholinesterase properties of Tunisian Origanum majorana L. essential oil. Microb Pathog. 2016;95:86–94.10.1016/j.micpath.2016.03.003Search in Google Scholar PubMed
[36] Kadoglidou K, Lagopodi A, Karamanoli K, Vokou D, Bardas GA, Menexes G, et al. Inhibitory and stimulatory effects of essential oils and individual monoterpenoids on growth and sporulation of four soil-borne fungal isolates of Aspergillus terreus, Fusarium oxysporum, Penicillium expansum, and Verticillium dahliae. Eur J Plant Pathol. 2011;130(3):297–309.10.1007/s10658-011-9754-xSearch in Google Scholar
[37] Vagi E, Simándi B, Daood HG, Deak A, Sawinsky J. Recovery of pigments from Origanum majorana L. by extraction with supercritical carbon dioxide. J Agric Food Chem. 2002;50(8):2297–301.10.1021/jf0112872Search in Google Scholar PubMed
[38] Adam SI, Ahmed TG. Phytochemical screening and biological effect of indigenous medicinal plant origanum majorana extracts. J Fac Sci Technol. 2014;5:85–97.Search in Google Scholar
[39] Manganyi MC, Regnier T, Olivier EI. Antimicrobial activities of selected essential oils against Fusarium oxysporum isolates and their biofilms. South Afr J Bot. 2015;99:115–21.10.1016/j.sajb.2015.03.192Search in Google Scholar
© 2023 the author(s), published by De Gruyter
This work is licensed under the Creative Commons Attribution 4.0 International License.
Articles in the same Issue
- Characteristics, source, and health risk assessment of aerosol polyaromatic hydrocarbons in the rural and urban regions of western Saudi Arabia
- Regular Articles
- A network-based correlation research between element electronegativity and node importance
- Pomegranate attenuates kidney injury in cyclosporine-induced nephrotoxicity in rats by suppressing oxidative stress
- Ab initio study of fundamental properties of XInO3 (X = K, Rb, Cs) perovskites
- Responses of feldspathic sandstone and sand-reconstituted soil C and N to freeze–thaw cycles
- Robust fractional control based on high gain observers design (RNFC) for a Spirulina maxima culture interfaced with an advanced oxidation process
- Study on arsenic speciation and redistribution mechanism in Lonicera japonica plants via synchrotron techniques
- Optimization of machining Nilo 36 superalloy parameters in turning operation
- Vacuum impregnation pre-treatment: A novel method for incorporating mono- and divalent cations into potato strips to reduce the acrylamide formation in French fries
- Characterization of effective constituents in Acanthopanax senticosus fruit for blood deficiency syndrome based on the chinmedomics strategy
- Comparative analysis of the metabolites in Pinellia ternata from two producing regions using ultra-high-performance liquid chromatography–electrospray ionization–tandem mass spectrometry
- The assessment of environmental parameter along the desalination plants in the Kingdom of Saudi Arabia
- Effects of harpin and carbendazim on antioxidant accumulation in young jujube leaves
- The effects of in ovo injected with sodium borate on hatching performance and small intestine morphology in broiler chicks
- Optimization of cutting forces and surface roughness via ANOVA and grey relational analysis in machining of In718
- Essential oils of Origanum compactum Benth: Chemical characterization, in vitro, in silico, antioxidant, and antibacterial activities
- Translocation of tungsten(vi) oxide/gadolinium(iii) fluoride in tellurite glasses towards improvement of gamma-ray attenuation features in high-density glass shields
- Mechanical properties, elastic moduli, and gamma ray attenuation competencies of some TeO2–WO3–GdF3 glasses: Tailoring WO3–GdF3 substitution toward optimum behavioral state range
- Comparison between the CIDR or sponge with hormone injection to induce estrus synchronization for twining and sex preselection in Naimi sheep
- Exergetic performance analyses of three different cogeneration plants
- Psoralea corylifolia (babchi) seeds enhance proliferation of normal human cultured melanocytes: GC–MS profiling and biological investigation
- A novel electrochemical micro-titration method for quantitative evaluation of the DPPH free radical scavenging capacity of caffeic acid
- Comparative study between supported bimetallic catalysts for nitrate remediation in water
- Persicaline, an alkaloid from Salvadora persica, inhibits proliferation and induces apoptosis and cell-cycle arrest in MCF-7 cells
- Determination of nicotine content in locally produced smokeless tobacco (Shammah) samples from Jazan region of Saudi Arabia using a convenient HPLC-MS/MS method
- Changes in oxidative stress markers in pediatric burn injury over a 1-week period
- Integrated geophysical techniques applied for petroleum basins structural characterization in the central part of the Western Desert, Egypt
- The impact of chemical modifications on gamma-ray attenuation properties of some WO3-reinforced tellurite glasses
- Microwave and Cs+-assisted chemo selective reaction protocol for synthesizing 2-styryl quinoline biorelevant molecules
- Structural, physical, and radiation absorption properties of a significant nuclear power plant component: A comparison between REX-734 and 316L SS austenitic stainless steels
- Effect of Moringa oleifera on serum YKL-40 level: In vivo rat periodontitis model
- Investigating the impact of CO2 emissions on the COVID-19 pandemic by generalized linear mixed model approach with inverse Gaussian and gamma distributions
- Influence of WO3 content on gamma rays attenuation characteristics of phosphate glasses at low energy range
- Study on CO2 absorption performance of ternary DES formed based on DEA as promoting factor
- Performance analyses of detonation engine cogeneration cycles
- Sterols from Centaurea pumilio L. with cell proliferative activity: In vitro and in silico studies
- Untargeted metabolomics revealing changes in aroma substances in flue-cured tobacco
- Effect of pumpkin enriched with calcium lactate on iron status in an animal model of postmenopausal osteoporosis
- Energy consumption, mechanical and metallographic properties of cryogenically treated tool steels
- Optimization of ultra-high pressure-assisted extraction of total phenols from Eucommia ulmoides leaves by response surface methodology
- Harpin enhances antioxidant nutrient accumulation and decreases enzymatic browning in stored soybean sprouts
- Physicochemical and biological properties of carvacrol
- Radix puerariae in the treatment of diabetic nephropathy: A network pharmacology analysis and experimental validation
- Anti-Alzheimer, antioxidants, glucose-6-phosphate dehydrogenase effects of Taverniera glabra mediated ZnO and Fe2O3 nanoparticles in alloxan-induced diabetic rats
- Experimental study on photocatalytic CO2 reduction performance of ZnS/CdS-TiO2 nanotube array thin films
- Epoxy-reinforced heavy metal oxides for gamma ray shielding purposes
- Black mulberry (Morus nigra L.) fruits: As a medicinal plant rich in human health-promoting compounds
- Promising antioxidant and antimicrobial effects of essential oils extracted from fruits of Juniperus thurifera: In vitro and in silico investigations
- Chloramine-T-induced oxidation of Rizatriptan Benzoate: An integral chemical and spectroscopic study of products, mechanisms and kinetics
- Study on antioxidant and antimicrobial potential of chemically profiled essential oils extracted from Juniperus phoenicea (L.) by use of in vitro and in silico approaches
- Screening and characterization of fungal taxol-producing endophytic fungi for evaluation of antimicrobial and anticancer activities
- Mineral composition, principal polyphenolic components, and evaluation of the anti-inflammatory, analgesic, and antioxidant properties of Cytisus villosus Pourr leaf extracts
- In vitro antiproliferative efficacy of Annona muricata seed and fruit extracts on several cancer cell lines
- An experimental study for chemical characterization of artificial anterior cruciate ligament with coated chitosan as biomaterial
- Prevalence of residual risks of the transfusion-transmitted infections in Riyadh hospitals: A two-year retrospective study
- Computational and experimental investigation of antibacterial and antifungal properties of Nicotiana tabacum extracts
- Reinforcement of cementitious mortars with hemp fibers and shives
- X-ray shielding properties of bismuth-borate glass doped with rare earth ions
- Green supported silver nanoparticles over modified reduced graphene oxide: Investigation of its antioxidant and anti-ovarian cancer effects
- Orthogonal synthesis of a versatile building block for dual functionalization of targeting vectors
- Thymbra spicata leaf extract driven biogenic synthesis of Au/Fe3O4 nanocomposite and its bio-application in the treatment of different types of leukemia
- The role of Ag2O incorporation in nuclear radiation shielding behaviors of the Li2O–Pb3O4–SiO2 glass system: A multi-step characterization study
- A stimuli-responsive in situ spray hydrogel co-loaded with naringenin and gentamicin for chronic wounds
- Assessment of the impact of γ-irradiation on the piperine content and microbial quality of black pepper
- Antioxidant, sensory, and functional properties of low-alcoholic IPA beer with Pinus sylvestris L. shoots addition fermented using unconventional yeast
- Screening and optimization of extracellular pectinase produced by Bacillus thuringiensis SH7
- Determination of polyphenols in Chinese jujube using ultra-performance liquid chromatography–mass spectrometry
- Synergistic effects of harpin and NaCl in determining soybean sprout quality under non-sterile conditions
- Field evaluation of different eco-friendly alternative control methods against Panonychus citri [Acari: Tetranychidae] spider mite and its predators in citrus orchards
- Exploring the antimicrobial potential of biologically synthesized zero valent iron nanoparticles
- NaCl regulates goldfish growth and survival at three food supply levels under hypoxia
- An exploration of the physical, optical, mechanical, and radiation shielding properties of PbO–MgO–ZnO–B2O3 glasses
- A novel statistical modeling of air pollution and the COVID-19 pandemic mortality data by Poisson, geometric, and negative binomial regression models with fixed and random effects
- Treatment activity of the injectable hydrogels loaded with dexamethasone In(iii) complex on glioma by inhibiting the VEGF signaling pathway
- An alternative approach for the excess lifetime cancer risk and prediction of radiological parameters
- Panax ginseng leaf aqueous extract mediated green synthesis of AgNPs under ultrasound condition and investigation of its anti-lung adenocarcinoma effects
- Study of hydrolysis and production of instant ginger (Zingiber officinale) tea
- Novel green synthesis of zinc oxide nanoparticles using Salvia rosmarinus extract for treatment of human lung cancer
- Evaluation of second trimester plasma lipoxin A4, VEGFR-1, IL-6, and TNF-α levels in pregnant women with gestational diabetes mellitus
- Antidiabetic, antioxidant and cytotoxicity activities of ortho- and para-substituted Schiff bases derived from metformin hydrochloride: Validation by molecular docking and in silico ADME studies
- Antioxidant, antidiabetic, antiglaucoma, and anticholinergic effects of Tayfi grape (Vitis vinifera): A phytochemical screening by LC-MS/MS analysis
- Identification of genetic polymorphisms in the stearoyl CoA desaturase gene and its association with milk quality traits in Najdi sheep
- Cold-acclimation effect on cadmium absorption and biosynthesis of polyphenolics, and free proline and photosynthetic pigments in Spirogyra aequinoctialis
- Analysis of secondary metabolites in Xinjiang Morus nigra leaves using different extraction methods with UPLC-Q/TOF-MS/MS technology
- Nanoarchitectonics and performance evaluation of a Fe3O4-stabilized Pickering emulsion-type differential pressure plugging agent
- Investigating pyrolysis characteristics of Shengdong coal through Py-GC/MS
- Extraction, phytochemical characterization, and antifungal activity of Salvia rosmarinus extract
- Introducing a novel and natural antibiotic for the treatment of oral pathogens: Abelmoschus esculentus green-formulated silver nanoparticles
- Optimization of gallic acid-enriched ultrasonic-assisted extraction from mango peels
- Effect of gamma rays irradiation in the structure, optical, and electrical properties of samarium doped bismuth titanate ceramics
- Combinatory in silico investigation for potential inhibitors from Curcuma sahuynhensis Škorničk. & N.S. Lý volatile phytoconstituents against influenza A hemagglutinin, SARS-CoV-2 main protease, and Omicron-variant spike protein
- Physical, mechanical, and gamma ray shielding properties of the Bi2O3–BaO–B2O3–ZnO–As2O3–MgO–Na2O glass system
- Twofold interpenetrated 3D Cd(ii) complex: Crystal structure and luminescent property
- Study on the microstructure and soil quality variation of composite soil with soft rock and sand
- Ancient spring waters still emerging and accessible in the Roman Forum area: Chemical–physical and microbiological characterization
- Extraction and characterization of type I collagen from scales of Mexican Biajaiba fish
- Finding small molecular compounds to decrease trimethylamine oxide levels in atherosclerosis by virtual screening
- Prefatory in silico studies and in vitro insecticidal effect of Nigella sativa (L.) essential oil and its active compound (carvacrol) against the Callosobruchus maculatus adults (Fab), a major pest of chickpea
- Polymerized methyl imidazole silver bromide (CH3C6H5AgBr)6: Synthesis, crystal structures, and catalytic activity
- Using calcined waste fish bones as a green solid catalyst for biodiesel production from date seed oil
- Influence of the addition of WO3 on TeO2–Na2O glass systems in view of the feature of mechanical, optical, and photon attenuation
- Naringin ameliorates 5-fluorouracil elicited neurotoxicity by curtailing oxidative stress and iNOS/NF-ĸB/caspase-3 pathway
- GC-MS profile of extracts of an endophytic fungus Alternaria and evaluation of its anticancer and antibacterial potentialities
- Green synthesis, chemical characterization, and antioxidant and anti-colorectal cancer effects of vanadium nanoparticles
- Determination of caffeine content in coffee drinks prepared in some coffee shops in the local market in Jeddah City, Saudi Arabia
- A new 3D supramolecular Cu(ii) framework: Crystal structure and photocatalytic characteristics
- Bordeaux mixture accelerates ripening, delays senescence, and promotes metabolite accumulation in jujube fruit
- Important application value of injectable hydrogels loaded with omeprazole Schiff base complex in the treatment of pancreatitis
- Color tunable benzothiadiazole-based small molecules for lightening applications
- Investigation of structural, dielectric, impedance, and mechanical properties of hydroxyapatite-modified barium titanate composites for biomedical applications
- Metal gel particles loaded with epidermal cell growth factor promote skin wound repair mechanism by regulating miRNA
- In vitro exploration of Hypsizygus ulmarius (Bull.) mushroom fruiting bodies: Potential antidiabetic and anti-inflammatory agent
- Alteration in the molecular structure of the adenine base exposed to gamma irradiation: An ESR study
- Comprehensive study of optical, thermal, and gamma-ray shielding properties of Bi2O3–ZnO–PbO–B2O3 glasses
- Lewis acids as co-catalysts in Pd-based catalyzed systems of the octene-1 hydroethoxycarbonylation reaction
- Synthesis, Hirshfeld surface analysis, thermal, and selective α-glucosidase inhibitory studies of Schiff base transition metal complexes
- Protective properties of AgNPs green-synthesized by Abelmoschus esculentus on retinal damage on the virtue of its anti-inflammatory and antioxidant effects in diabetic rat
- Effects of green decorated AgNPs on lignin-modified magnetic nanoparticles mediated by Cydonia on cecal ligation and puncture-induced sepsis
- Treatment of gastric cancer by green mediated silver nanoparticles using Pistacia atlantica bark aqueous extract
- Preparation of newly developed porcelain ceramics containing WO3 nanoparticles for radiation shielding applications
- Utilization of computational methods for the identification of new natural inhibitors of human neutrophil elastase in inflammation therapy
- Some anticancer agents as effective glutathione S-transferase (GST) inhibitors
- Clay-based bricks’ rich illite mineral for gamma-ray shielding applications: An experimental evaluation of the effect of pressure rates on gamma-ray attenuation parameters
- Stability kinetics of orevactaene pigments produced by Epicoccum nigrum in solid-state fermentation
- Treatment of denture stomatitis using iron nanoparticles green-synthesized by Silybum marianum extract
- Characterization and antioxidant potential of white mustard (Brassica hirta) leaf extract and stabilization of sunflower oil
- Characteristics of Langmuir monomolecular monolayers formed by the novel oil blends
- Strategies for optimizing the single GdSrFeO4 phase synthesis
- Oleic acid and linoleic acid nanosomes boost immunity and provoke cell death via the upregulation of beta-defensin-4 at genetic and epigenetic levels
- Unraveling the therapeutic potential of Bombax ceiba roots: A comprehensive study of chemical composition, heavy metal content, antibacterial activity, and in silico analysis
- Green synthesis of AgNPs using plant extract and investigation of its anti-human colorectal cancer application
- The adsorption of naproxen on adsorbents obtained from pepper stalk extract by green synthesis
- Treatment of gastric cancer by silver nanoparticles encapsulated by chitosan polymers mediated by Pistacia atlantica extract under ultrasound condition
- In vitro protective and anti-inflammatory effects of Capparis spinosa and its flavonoids profile
- Wear and corrosion behavior of TiC and WC coatings deposited on high-speed steels by electro-spark deposition
- Therapeutic effects of green-formulated gold nanoparticles by Origanum majorana on spinal cord injury in rats
- Melanin antibacterial activity of two new strains, SN1 and SN2, of Exophiala phaeomuriformis against five human pathogens
- Evaluation of the analgesic and anesthetic properties of silver nanoparticles supported over biodegradable acacia gum-modified magnetic nanoparticles
- Review Articles
- Role and mechanism of fruit waste polyphenols in diabetes management
- A comprehensive review of non-alkaloidal metabolites from the subfamily Amaryllidoideae (Amaryllidaceae)
- Discovery of the chemical constituents, structural characteristics, and pharmacological functions of Chinese caterpillar fungus
- Eco-friendly green approach of nickel oxide nanoparticles for biomedical applications
- Advances in the pharmaceutical research of curcumin for oral administration
- Rapid Communication
- Determination of the contents of bioactive compounds in St. John’s wort (Hypericum perforatum): Comparison of commercial and wild samples
- Retraction
- Retraction of “Two mixed-ligand coordination polymers based on 2,5-thiophenedicarboxylic acid and flexible N-donor ligands: The protective effect on periodontitis via reducing the release of IL-1β and TNF-α”
- Topical Issue on Phytochemicals, biological and toxicological analysis of aromatic medicinal plants
- Anti-plasmodial potential of selected medicinal plants and a compound Atropine isolated from Eucalyptus obliqua
- Anthocyanin extract from black rice attenuates chronic inflammation in DSS-induced colitis mouse model by modulating the gut microbiota
- Evaluation of antibiofilm and cytotoxicity effect of Rumex vesicarius methanol extract
- Chemical compositions of Litsea umbellata and inhibition activities
- Green synthesis, characterization of silver nanoparticles using Rhynchosia capitata leaf extract and their biological activities
- GC-MS analysis and antibacterial activities of some plants belonging to the genus Euphorbia on selected bacterial isolates
- The abrogative effect of propolis on acrylamide-induced toxicity in male albino rats: Histological study
- A phytoconstituent 6-aminoflavone ameliorates lipopolysaccharide-induced oxidative stress mediated synapse and memory dysfunction via p-Akt/NF-kB pathway in albino mice
- Anti-diabetic potentials of Sorbaria tomentosa Lindl. Rehder: Phytochemistry (GC-MS analysis), α-amylase, α-glucosidase inhibitory, in vivo hypoglycemic, and biochemical analysis
- Assessment of cytotoxic and apoptotic activities of the Cassia angustifolia aqueous extract against SW480 colon cancer
- Biochemical analysis, antioxidant, and antibacterial efficacy of the bee propolis extract (Hymenoptera: Apis mellifera) against Staphylococcus aureus-induced infection in BALB/c mice: In vitro and in vivo study
- Assessment of essential elements and heavy metals in Saudi Arabian rice samples underwent various processing methods
- Two new compounds from leaves of Capparis dongvanensis (Sy, B. H. Quang & D. V. Hai) and inhibition activities
- Hydroxyquinoline sulfanilamide ameliorates STZ-induced hyperglycemia-mediated amyleoid beta burden and memory impairment in adult mice
- An automated reading of semi-quantitative hemagglutination results in microplates: Micro-assay for plant lectins
- Inductively coupled plasma mass spectrometry assessment of essential and toxic trace elements in traditional spices consumed by the population of the Middle Eastern region in their recipes
- Phytochemical analysis and anticancer activity of the Pithecellobium dulce seed extract in colorectal cancer cells
- Impact of climatic disturbances on the chemical compositions and metabolites of Salvia officinalis
- Physicochemical characterization, antioxidant and antifungal activities of essential oils of Urginea maritima and Allium sativum
- Phytochemical analysis and antifungal efficiency of Origanum majorana extracts against some phytopathogenic fungi causing tomato damping-off diseases
- Special Issue on 4th IC3PE
- Graphene quantum dots: A comprehensive overview
- Studies on the intercalation of calcium–aluminium layered double hydroxide-MCPA and its controlled release mechanism as a potential green herbicide
- Synergetic effect of adsorption and photocatalysis by zinc ferrite-anchored graphitic carbon nitride nanosheet for the removal of ciprofloxacin under visible light irradiation
- Exploring anticancer activity of the Indonesian guava leaf (Psidium guajava L.) fraction on various human cancer cell lines in an in vitro cell-based approach
- The comparison of gold extraction methods from the rock using thiourea and thiosulfate
- Special Issue on Marine environmental sciences and significance of the multidisciplinary approaches
- Sorption of alkylphenols and estrogens on microplastics in marine conditions
- Cytotoxic ketosteroids from the Red Sea soft coral Dendronephthya sp.
- Antibacterial and biofilm prevention metabolites from Acanthophora spicifera
- Characteristics, source, and health risk assessment of aerosol polyaromatic hydrocarbons in the rural and urban regions of western Saudi Arabia
- Special Issue on Advanced Nanomaterials for Energy, Environmental and Biological Applications - Part II
- Green synthesis, characterization, and evaluation of antibacterial activities of cobalt nanoparticles produced by marine fungal species Periconia prolifica
- Combustion-mediated sol–gel preparation of cobalt-doped ZnO nanohybrids for the degradation of acid red and antibacterial performance
- Perinatal supplementation with selenium nanoparticles modified with ascorbic acid improves hepatotoxicity in rat gestational diabetes
- Evaluation and chemical characterization of bioactive secondary metabolites from endophytic fungi associated with the ethnomedicinal plant Bergenia ciliata
- Enhancing photovoltaic efficiency with SQI-Br and SQI-I sensitizers: A comparative analysis
- Nanostructured p-PbS/p-CuO sulfide/oxide bilayer heterojunction as a promising photoelectrode for hydrogen gas generation
Articles in the same Issue
- Characteristics, source, and health risk assessment of aerosol polyaromatic hydrocarbons in the rural and urban regions of western Saudi Arabia
- Regular Articles
- A network-based correlation research between element electronegativity and node importance
- Pomegranate attenuates kidney injury in cyclosporine-induced nephrotoxicity in rats by suppressing oxidative stress
- Ab initio study of fundamental properties of XInO3 (X = K, Rb, Cs) perovskites
- Responses of feldspathic sandstone and sand-reconstituted soil C and N to freeze–thaw cycles
- Robust fractional control based on high gain observers design (RNFC) for a Spirulina maxima culture interfaced with an advanced oxidation process
- Study on arsenic speciation and redistribution mechanism in Lonicera japonica plants via synchrotron techniques
- Optimization of machining Nilo 36 superalloy parameters in turning operation
- Vacuum impregnation pre-treatment: A novel method for incorporating mono- and divalent cations into potato strips to reduce the acrylamide formation in French fries
- Characterization of effective constituents in Acanthopanax senticosus fruit for blood deficiency syndrome based on the chinmedomics strategy
- Comparative analysis of the metabolites in Pinellia ternata from two producing regions using ultra-high-performance liquid chromatography–electrospray ionization–tandem mass spectrometry
- The assessment of environmental parameter along the desalination plants in the Kingdom of Saudi Arabia
- Effects of harpin and carbendazim on antioxidant accumulation in young jujube leaves
- The effects of in ovo injected with sodium borate on hatching performance and small intestine morphology in broiler chicks
- Optimization of cutting forces and surface roughness via ANOVA and grey relational analysis in machining of In718
- Essential oils of Origanum compactum Benth: Chemical characterization, in vitro, in silico, antioxidant, and antibacterial activities
- Translocation of tungsten(vi) oxide/gadolinium(iii) fluoride in tellurite glasses towards improvement of gamma-ray attenuation features in high-density glass shields
- Mechanical properties, elastic moduli, and gamma ray attenuation competencies of some TeO2–WO3–GdF3 glasses: Tailoring WO3–GdF3 substitution toward optimum behavioral state range
- Comparison between the CIDR or sponge with hormone injection to induce estrus synchronization for twining and sex preselection in Naimi sheep
- Exergetic performance analyses of three different cogeneration plants
- Psoralea corylifolia (babchi) seeds enhance proliferation of normal human cultured melanocytes: GC–MS profiling and biological investigation
- A novel electrochemical micro-titration method for quantitative evaluation of the DPPH free radical scavenging capacity of caffeic acid
- Comparative study between supported bimetallic catalysts for nitrate remediation in water
- Persicaline, an alkaloid from Salvadora persica, inhibits proliferation and induces apoptosis and cell-cycle arrest in MCF-7 cells
- Determination of nicotine content in locally produced smokeless tobacco (Shammah) samples from Jazan region of Saudi Arabia using a convenient HPLC-MS/MS method
- Changes in oxidative stress markers in pediatric burn injury over a 1-week period
- Integrated geophysical techniques applied for petroleum basins structural characterization in the central part of the Western Desert, Egypt
- The impact of chemical modifications on gamma-ray attenuation properties of some WO3-reinforced tellurite glasses
- Microwave and Cs+-assisted chemo selective reaction protocol for synthesizing 2-styryl quinoline biorelevant molecules
- Structural, physical, and radiation absorption properties of a significant nuclear power plant component: A comparison between REX-734 and 316L SS austenitic stainless steels
- Effect of Moringa oleifera on serum YKL-40 level: In vivo rat periodontitis model
- Investigating the impact of CO2 emissions on the COVID-19 pandemic by generalized linear mixed model approach with inverse Gaussian and gamma distributions
- Influence of WO3 content on gamma rays attenuation characteristics of phosphate glasses at low energy range
- Study on CO2 absorption performance of ternary DES formed based on DEA as promoting factor
- Performance analyses of detonation engine cogeneration cycles
- Sterols from Centaurea pumilio L. with cell proliferative activity: In vitro and in silico studies
- Untargeted metabolomics revealing changes in aroma substances in flue-cured tobacco
- Effect of pumpkin enriched with calcium lactate on iron status in an animal model of postmenopausal osteoporosis
- Energy consumption, mechanical and metallographic properties of cryogenically treated tool steels
- Optimization of ultra-high pressure-assisted extraction of total phenols from Eucommia ulmoides leaves by response surface methodology
- Harpin enhances antioxidant nutrient accumulation and decreases enzymatic browning in stored soybean sprouts
- Physicochemical and biological properties of carvacrol
- Radix puerariae in the treatment of diabetic nephropathy: A network pharmacology analysis and experimental validation
- Anti-Alzheimer, antioxidants, glucose-6-phosphate dehydrogenase effects of Taverniera glabra mediated ZnO and Fe2O3 nanoparticles in alloxan-induced diabetic rats
- Experimental study on photocatalytic CO2 reduction performance of ZnS/CdS-TiO2 nanotube array thin films
- Epoxy-reinforced heavy metal oxides for gamma ray shielding purposes
- Black mulberry (Morus nigra L.) fruits: As a medicinal plant rich in human health-promoting compounds
- Promising antioxidant and antimicrobial effects of essential oils extracted from fruits of Juniperus thurifera: In vitro and in silico investigations
- Chloramine-T-induced oxidation of Rizatriptan Benzoate: An integral chemical and spectroscopic study of products, mechanisms and kinetics
- Study on antioxidant and antimicrobial potential of chemically profiled essential oils extracted from Juniperus phoenicea (L.) by use of in vitro and in silico approaches
- Screening and characterization of fungal taxol-producing endophytic fungi for evaluation of antimicrobial and anticancer activities
- Mineral composition, principal polyphenolic components, and evaluation of the anti-inflammatory, analgesic, and antioxidant properties of Cytisus villosus Pourr leaf extracts
- In vitro antiproliferative efficacy of Annona muricata seed and fruit extracts on several cancer cell lines
- An experimental study for chemical characterization of artificial anterior cruciate ligament with coated chitosan as biomaterial
- Prevalence of residual risks of the transfusion-transmitted infections in Riyadh hospitals: A two-year retrospective study
- Computational and experimental investigation of antibacterial and antifungal properties of Nicotiana tabacum extracts
- Reinforcement of cementitious mortars with hemp fibers and shives
- X-ray shielding properties of bismuth-borate glass doped with rare earth ions
- Green supported silver nanoparticles over modified reduced graphene oxide: Investigation of its antioxidant and anti-ovarian cancer effects
- Orthogonal synthesis of a versatile building block for dual functionalization of targeting vectors
- Thymbra spicata leaf extract driven biogenic synthesis of Au/Fe3O4 nanocomposite and its bio-application in the treatment of different types of leukemia
- The role of Ag2O incorporation in nuclear radiation shielding behaviors of the Li2O–Pb3O4–SiO2 glass system: A multi-step characterization study
- A stimuli-responsive in situ spray hydrogel co-loaded with naringenin and gentamicin for chronic wounds
- Assessment of the impact of γ-irradiation on the piperine content and microbial quality of black pepper
- Antioxidant, sensory, and functional properties of low-alcoholic IPA beer with Pinus sylvestris L. shoots addition fermented using unconventional yeast
- Screening and optimization of extracellular pectinase produced by Bacillus thuringiensis SH7
- Determination of polyphenols in Chinese jujube using ultra-performance liquid chromatography–mass spectrometry
- Synergistic effects of harpin and NaCl in determining soybean sprout quality under non-sterile conditions
- Field evaluation of different eco-friendly alternative control methods against Panonychus citri [Acari: Tetranychidae] spider mite and its predators in citrus orchards
- Exploring the antimicrobial potential of biologically synthesized zero valent iron nanoparticles
- NaCl regulates goldfish growth and survival at three food supply levels under hypoxia
- An exploration of the physical, optical, mechanical, and radiation shielding properties of PbO–MgO–ZnO–B2O3 glasses
- A novel statistical modeling of air pollution and the COVID-19 pandemic mortality data by Poisson, geometric, and negative binomial regression models with fixed and random effects
- Treatment activity of the injectable hydrogels loaded with dexamethasone In(iii) complex on glioma by inhibiting the VEGF signaling pathway
- An alternative approach for the excess lifetime cancer risk and prediction of radiological parameters
- Panax ginseng leaf aqueous extract mediated green synthesis of AgNPs under ultrasound condition and investigation of its anti-lung adenocarcinoma effects
- Study of hydrolysis and production of instant ginger (Zingiber officinale) tea
- Novel green synthesis of zinc oxide nanoparticles using Salvia rosmarinus extract for treatment of human lung cancer
- Evaluation of second trimester plasma lipoxin A4, VEGFR-1, IL-6, and TNF-α levels in pregnant women with gestational diabetes mellitus
- Antidiabetic, antioxidant and cytotoxicity activities of ortho- and para-substituted Schiff bases derived from metformin hydrochloride: Validation by molecular docking and in silico ADME studies
- Antioxidant, antidiabetic, antiglaucoma, and anticholinergic effects of Tayfi grape (Vitis vinifera): A phytochemical screening by LC-MS/MS analysis
- Identification of genetic polymorphisms in the stearoyl CoA desaturase gene and its association with milk quality traits in Najdi sheep
- Cold-acclimation effect on cadmium absorption and biosynthesis of polyphenolics, and free proline and photosynthetic pigments in Spirogyra aequinoctialis
- Analysis of secondary metabolites in Xinjiang Morus nigra leaves using different extraction methods with UPLC-Q/TOF-MS/MS technology
- Nanoarchitectonics and performance evaluation of a Fe3O4-stabilized Pickering emulsion-type differential pressure plugging agent
- Investigating pyrolysis characteristics of Shengdong coal through Py-GC/MS
- Extraction, phytochemical characterization, and antifungal activity of Salvia rosmarinus extract
- Introducing a novel and natural antibiotic for the treatment of oral pathogens: Abelmoschus esculentus green-formulated silver nanoparticles
- Optimization of gallic acid-enriched ultrasonic-assisted extraction from mango peels
- Effect of gamma rays irradiation in the structure, optical, and electrical properties of samarium doped bismuth titanate ceramics
- Combinatory in silico investigation for potential inhibitors from Curcuma sahuynhensis Škorničk. & N.S. Lý volatile phytoconstituents against influenza A hemagglutinin, SARS-CoV-2 main protease, and Omicron-variant spike protein
- Physical, mechanical, and gamma ray shielding properties of the Bi2O3–BaO–B2O3–ZnO–As2O3–MgO–Na2O glass system
- Twofold interpenetrated 3D Cd(ii) complex: Crystal structure and luminescent property
- Study on the microstructure and soil quality variation of composite soil with soft rock and sand
- Ancient spring waters still emerging and accessible in the Roman Forum area: Chemical–physical and microbiological characterization
- Extraction and characterization of type I collagen from scales of Mexican Biajaiba fish
- Finding small molecular compounds to decrease trimethylamine oxide levels in atherosclerosis by virtual screening
- Prefatory in silico studies and in vitro insecticidal effect of Nigella sativa (L.) essential oil and its active compound (carvacrol) against the Callosobruchus maculatus adults (Fab), a major pest of chickpea
- Polymerized methyl imidazole silver bromide (CH3C6H5AgBr)6: Synthesis, crystal structures, and catalytic activity
- Using calcined waste fish bones as a green solid catalyst for biodiesel production from date seed oil
- Influence of the addition of WO3 on TeO2–Na2O glass systems in view of the feature of mechanical, optical, and photon attenuation
- Naringin ameliorates 5-fluorouracil elicited neurotoxicity by curtailing oxidative stress and iNOS/NF-ĸB/caspase-3 pathway
- GC-MS profile of extracts of an endophytic fungus Alternaria and evaluation of its anticancer and antibacterial potentialities
- Green synthesis, chemical characterization, and antioxidant and anti-colorectal cancer effects of vanadium nanoparticles
- Determination of caffeine content in coffee drinks prepared in some coffee shops in the local market in Jeddah City, Saudi Arabia
- A new 3D supramolecular Cu(ii) framework: Crystal structure and photocatalytic characteristics
- Bordeaux mixture accelerates ripening, delays senescence, and promotes metabolite accumulation in jujube fruit
- Important application value of injectable hydrogels loaded with omeprazole Schiff base complex in the treatment of pancreatitis
- Color tunable benzothiadiazole-based small molecules for lightening applications
- Investigation of structural, dielectric, impedance, and mechanical properties of hydroxyapatite-modified barium titanate composites for biomedical applications
- Metal gel particles loaded with epidermal cell growth factor promote skin wound repair mechanism by regulating miRNA
- In vitro exploration of Hypsizygus ulmarius (Bull.) mushroom fruiting bodies: Potential antidiabetic and anti-inflammatory agent
- Alteration in the molecular structure of the adenine base exposed to gamma irradiation: An ESR study
- Comprehensive study of optical, thermal, and gamma-ray shielding properties of Bi2O3–ZnO–PbO–B2O3 glasses
- Lewis acids as co-catalysts in Pd-based catalyzed systems of the octene-1 hydroethoxycarbonylation reaction
- Synthesis, Hirshfeld surface analysis, thermal, and selective α-glucosidase inhibitory studies of Schiff base transition metal complexes
- Protective properties of AgNPs green-synthesized by Abelmoschus esculentus on retinal damage on the virtue of its anti-inflammatory and antioxidant effects in diabetic rat
- Effects of green decorated AgNPs on lignin-modified magnetic nanoparticles mediated by Cydonia on cecal ligation and puncture-induced sepsis
- Treatment of gastric cancer by green mediated silver nanoparticles using Pistacia atlantica bark aqueous extract
- Preparation of newly developed porcelain ceramics containing WO3 nanoparticles for radiation shielding applications
- Utilization of computational methods for the identification of new natural inhibitors of human neutrophil elastase in inflammation therapy
- Some anticancer agents as effective glutathione S-transferase (GST) inhibitors
- Clay-based bricks’ rich illite mineral for gamma-ray shielding applications: An experimental evaluation of the effect of pressure rates on gamma-ray attenuation parameters
- Stability kinetics of orevactaene pigments produced by Epicoccum nigrum in solid-state fermentation
- Treatment of denture stomatitis using iron nanoparticles green-synthesized by Silybum marianum extract
- Characterization and antioxidant potential of white mustard (Brassica hirta) leaf extract and stabilization of sunflower oil
- Characteristics of Langmuir monomolecular monolayers formed by the novel oil blends
- Strategies for optimizing the single GdSrFeO4 phase synthesis
- Oleic acid and linoleic acid nanosomes boost immunity and provoke cell death via the upregulation of beta-defensin-4 at genetic and epigenetic levels
- Unraveling the therapeutic potential of Bombax ceiba roots: A comprehensive study of chemical composition, heavy metal content, antibacterial activity, and in silico analysis
- Green synthesis of AgNPs using plant extract and investigation of its anti-human colorectal cancer application
- The adsorption of naproxen on adsorbents obtained from pepper stalk extract by green synthesis
- Treatment of gastric cancer by silver nanoparticles encapsulated by chitosan polymers mediated by Pistacia atlantica extract under ultrasound condition
- In vitro protective and anti-inflammatory effects of Capparis spinosa and its flavonoids profile
- Wear and corrosion behavior of TiC and WC coatings deposited on high-speed steels by electro-spark deposition
- Therapeutic effects of green-formulated gold nanoparticles by Origanum majorana on spinal cord injury in rats
- Melanin antibacterial activity of two new strains, SN1 and SN2, of Exophiala phaeomuriformis against five human pathogens
- Evaluation of the analgesic and anesthetic properties of silver nanoparticles supported over biodegradable acacia gum-modified magnetic nanoparticles
- Review Articles
- Role and mechanism of fruit waste polyphenols in diabetes management
- A comprehensive review of non-alkaloidal metabolites from the subfamily Amaryllidoideae (Amaryllidaceae)
- Discovery of the chemical constituents, structural characteristics, and pharmacological functions of Chinese caterpillar fungus
- Eco-friendly green approach of nickel oxide nanoparticles for biomedical applications
- Advances in the pharmaceutical research of curcumin for oral administration
- Rapid Communication
- Determination of the contents of bioactive compounds in St. John’s wort (Hypericum perforatum): Comparison of commercial and wild samples
- Retraction
- Retraction of “Two mixed-ligand coordination polymers based on 2,5-thiophenedicarboxylic acid and flexible N-donor ligands: The protective effect on periodontitis via reducing the release of IL-1β and TNF-α”
- Topical Issue on Phytochemicals, biological and toxicological analysis of aromatic medicinal plants
- Anti-plasmodial potential of selected medicinal plants and a compound Atropine isolated from Eucalyptus obliqua
- Anthocyanin extract from black rice attenuates chronic inflammation in DSS-induced colitis mouse model by modulating the gut microbiota
- Evaluation of antibiofilm and cytotoxicity effect of Rumex vesicarius methanol extract
- Chemical compositions of Litsea umbellata and inhibition activities
- Green synthesis, characterization of silver nanoparticles using Rhynchosia capitata leaf extract and their biological activities
- GC-MS analysis and antibacterial activities of some plants belonging to the genus Euphorbia on selected bacterial isolates
- The abrogative effect of propolis on acrylamide-induced toxicity in male albino rats: Histological study
- A phytoconstituent 6-aminoflavone ameliorates lipopolysaccharide-induced oxidative stress mediated synapse and memory dysfunction via p-Akt/NF-kB pathway in albino mice
- Anti-diabetic potentials of Sorbaria tomentosa Lindl. Rehder: Phytochemistry (GC-MS analysis), α-amylase, α-glucosidase inhibitory, in vivo hypoglycemic, and biochemical analysis
- Assessment of cytotoxic and apoptotic activities of the Cassia angustifolia aqueous extract against SW480 colon cancer
- Biochemical analysis, antioxidant, and antibacterial efficacy of the bee propolis extract (Hymenoptera: Apis mellifera) against Staphylococcus aureus-induced infection in BALB/c mice: In vitro and in vivo study
- Assessment of essential elements and heavy metals in Saudi Arabian rice samples underwent various processing methods
- Two new compounds from leaves of Capparis dongvanensis (Sy, B. H. Quang & D. V. Hai) and inhibition activities
- Hydroxyquinoline sulfanilamide ameliorates STZ-induced hyperglycemia-mediated amyleoid beta burden and memory impairment in adult mice
- An automated reading of semi-quantitative hemagglutination results in microplates: Micro-assay for plant lectins
- Inductively coupled plasma mass spectrometry assessment of essential and toxic trace elements in traditional spices consumed by the population of the Middle Eastern region in their recipes
- Phytochemical analysis and anticancer activity of the Pithecellobium dulce seed extract in colorectal cancer cells
- Impact of climatic disturbances on the chemical compositions and metabolites of Salvia officinalis
- Physicochemical characterization, antioxidant and antifungal activities of essential oils of Urginea maritima and Allium sativum
- Phytochemical analysis and antifungal efficiency of Origanum majorana extracts against some phytopathogenic fungi causing tomato damping-off diseases
- Special Issue on 4th IC3PE
- Graphene quantum dots: A comprehensive overview
- Studies on the intercalation of calcium–aluminium layered double hydroxide-MCPA and its controlled release mechanism as a potential green herbicide
- Synergetic effect of adsorption and photocatalysis by zinc ferrite-anchored graphitic carbon nitride nanosheet for the removal of ciprofloxacin under visible light irradiation
- Exploring anticancer activity of the Indonesian guava leaf (Psidium guajava L.) fraction on various human cancer cell lines in an in vitro cell-based approach
- The comparison of gold extraction methods from the rock using thiourea and thiosulfate
- Special Issue on Marine environmental sciences and significance of the multidisciplinary approaches
- Sorption of alkylphenols and estrogens on microplastics in marine conditions
- Cytotoxic ketosteroids from the Red Sea soft coral Dendronephthya sp.
- Antibacterial and biofilm prevention metabolites from Acanthophora spicifera
- Characteristics, source, and health risk assessment of aerosol polyaromatic hydrocarbons in the rural and urban regions of western Saudi Arabia
- Special Issue on Advanced Nanomaterials for Energy, Environmental and Biological Applications - Part II
- Green synthesis, characterization, and evaluation of antibacterial activities of cobalt nanoparticles produced by marine fungal species Periconia prolifica
- Combustion-mediated sol–gel preparation of cobalt-doped ZnO nanohybrids for the degradation of acid red and antibacterial performance
- Perinatal supplementation with selenium nanoparticles modified with ascorbic acid improves hepatotoxicity in rat gestational diabetes
- Evaluation and chemical characterization of bioactive secondary metabolites from endophytic fungi associated with the ethnomedicinal plant Bergenia ciliata
- Enhancing photovoltaic efficiency with SQI-Br and SQI-I sensitizers: A comparative analysis
- Nanostructured p-PbS/p-CuO sulfide/oxide bilayer heterojunction as a promising photoelectrode for hydrogen gas generation


